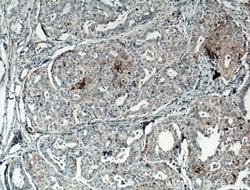
CD82 Rabbit anti-Human, Mouse, Polyclonal, Proteintech 20 &mu;L; Unconjugated:Antibodies,

missing translation for 'onlineSavingsMsg'
Learn More
Learn More
CD82 Rabbit anti-Human, Mouse, Polyclonal, Proteintech
Rabbit Polyclonal Antibody
Brand: Proteintech 10248-1-AP-20UL
This item is not returnable.
View return policy
Description
This metastasis suppressor gene product is a membrane glycoprotein that is a member of the transmembrane 4 superfamily. Expression of this gene has been shown to be downregulated in tumor progression of human cancers and can be activated by p53 through a consensus binding sequence in the promoter. Its expression and that of p53 are strongly correlated, and the loss of expression of these two proteins is associated with poor survival for prostate cancer patients. Two alternatively spliced transcript variants encoding distinct isoforms have been found for this gene.Specifications
| CD82 | |
| Polyclonal | |
| Unconjugated | |
| CD82 | |
| 4F9, C33, C33 antigen, CD82 antigen, CD82 molecule, CD82, KAI1, GR15, IA4, Inducible membrane protein R2, KAI1, Metastasis suppressor Kangai 1, R2, SAR2, ST6, Tetraspanin 27, Tspan 27, TSPAN27 | |
| Rabbit | |
| Antigen Affinity Chromatography | |
| RUO | |
| 12521, 3732 | |
| -20°C | |
| Liquid |
| Western Blot, Immunohistochemistry (Paraffin) | |
| 0.19 mg/mL | |
| PBS with 50% glycerol and 0.1% sodium azide; pH 7.3 | |
| P27701, P40237 | |
| CD82 | |
| CD82 Fusion Protein Ag0314 | |
| 20 μL | |
| Primary | |
| Human, Mouse | |
| Antibody | |
| IgG |
Product Content Correction
Your input is important to us. Please complete this form to provide feedback related to the content on this product.
Product Title
Spot an opportunity for improvement?Share a Content Correction